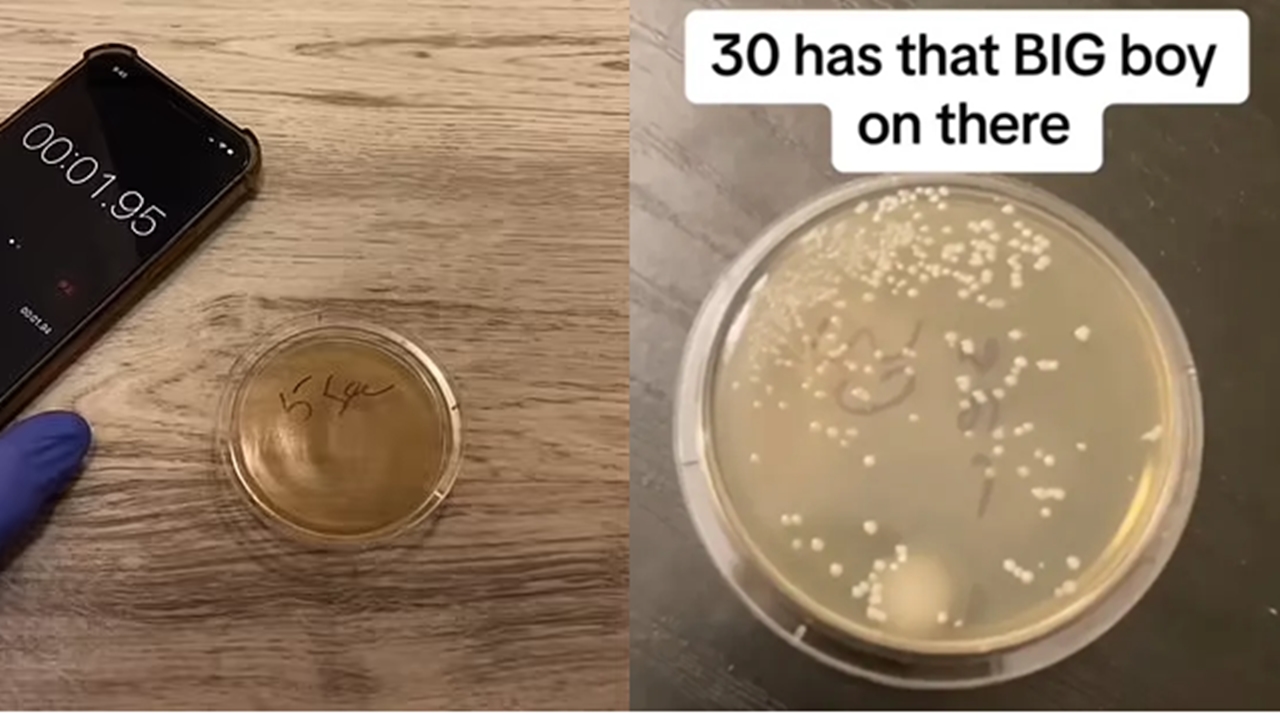

이미지 확대 보기
인스타그램
AD
음식을 떨어뜨려도 3초 안에 주워 먹으면 괜찮다는 속설이 있다. 해외에서는 3초가 아닌 5초로 널리 알려졌는데, 사실인지 검증해 본 미생물학자의 실험이 눈길을 끌고 있다.
16일(현지 시간) 영국 데일리메일에 따르면 미국 시카고의 품질 관리 분석 책임자인 니콜라스 아이처는 음식물이 바닥에 떨어졌을 때 1초, 5초, 10초, 20초, 30초, 그리고 1분 동안 떨어진 상태로 놔둔 후 세균 증식을 측정한 결과를 공개했다.
해당 실험은 각각의 시간대에 맞춰 세균 배양 접시를 바닥에 놓고 일정 시간 동안 세균의 성장을 관찰하는 식으로 진행됐다. 실험 결과 모든 샘플에서 세균이 자라났고, 심지어 1초가 되지 않은 샘플에서도 세균 증식이 확인됐다.
특히 1분간 바닥에 놓은 샘플이 5초 샘플과 비슷한 양의 세균을 보였다. 이와 관련해 아이처는 "5초든 60초든, 어차피 더럽다"고 설명했다.
실제로 바닥이나 일반적인 주방 표면은 살모넬라, 리스테리아 같은 박테리아가 가득할 수 있어 음식이 닿는 즉시 오염될 위험이 높다. 이러한 박테리아들은 식중독의 주범으로, 독소를 배출하며 질병을 유발합니다.
해당 영상은 200만회 이상 조회되며 논쟁을 불러일으켰다. 현지 누리꾼들은 "떨어진 음식은 쳐다도 안 봐야겠다"는 반응을 보인 한편 "어렸을 때부터 5초 룰을 지켰는데 아직 건강하다"는 반응도 공존했다.
YTN digital 이유나 (lyn@ytn.co.kr)
[저작권자(c) YTN 무단전재, 재배포 및 AI 데이터 활용 금지]
16일(현지 시간) 영국 데일리메일에 따르면 미국 시카고의 품질 관리 분석 책임자인 니콜라스 아이처는 음식물이 바닥에 떨어졌을 때 1초, 5초, 10초, 20초, 30초, 그리고 1분 동안 떨어진 상태로 놔둔 후 세균 증식을 측정한 결과를 공개했다.
해당 실험은 각각의 시간대에 맞춰 세균 배양 접시를 바닥에 놓고 일정 시간 동안 세균의 성장을 관찰하는 식으로 진행됐다. 실험 결과 모든 샘플에서 세균이 자라났고, 심지어 1초가 되지 않은 샘플에서도 세균 증식이 확인됐다.
특히 1분간 바닥에 놓은 샘플이 5초 샘플과 비슷한 양의 세균을 보였다. 이와 관련해 아이처는 "5초든 60초든, 어차피 더럽다"고 설명했다.
실제로 바닥이나 일반적인 주방 표면은 살모넬라, 리스테리아 같은 박테리아가 가득할 수 있어 음식이 닿는 즉시 오염될 위험이 높다. 이러한 박테리아들은 식중독의 주범으로, 독소를 배출하며 질병을 유발합니다.
해당 영상은 200만회 이상 조회되며 논쟁을 불러일으켰다. 현지 누리꾼들은 "떨어진 음식은 쳐다도 안 봐야겠다"는 반응을 보인 한편 "어렸을 때부터 5초 룰을 지켰는데 아직 건강하다"는 반응도 공존했다.
YTN digital 이유나 (lyn@ytn.co.kr)
[저작권자(c) YTN 무단전재, 재배포 및 AI 데이터 활용 금지]